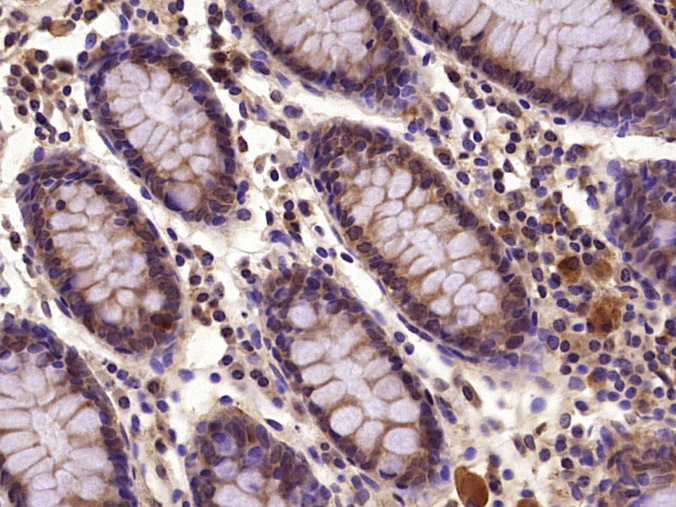
PIK3R2 Rabbit pAb(bs-4160R)-50

相关产品推荐更多 >
万千商家帮你免费找货
0 人在求购买到急需产品
- 详细信息
- 文献和实验
- 技术资料
- 应用范围:
产品信息以Bioss网站为准
- 规格:
50ul/100ul/200ul
| 规格: | 50ul | 产品价格: | ¥1180.0 |
|---|---|---|---|
| 规格: | 100ul | 产品价格: | ¥1980.0 |
| 规格: | 200ul | 产品价格: | ¥2800.0 |
| 产品编号 | bs-4160R |
| 英文名称 | PIK3R2 Rabbit pAb |
| 中文名称 | 磷脂酰肌醇激酶p85β抗体 |
| 英文别名 | P85B_HUMAN; Phosphatidylinositol 3-kinase regulatory subunit beta; PI3-kinase regulatory subunit beta; PI3K regulatory subunit beta; PtdIns-3-kinase regulatory subunit beta; Phosphatidylinositol 3-kinase 85 kDa regulatory subunit beta(PI3-kinase subunit p85-beta; PtdIns-3-kinase regulatory subunit p85-beta); PI 3 Kinase p85 beta; PI 3-Kinase p85β; PI 3-Kinase p85-β; PI 3-Kinase p85 β; PI3 kinase p85 beta subunit; phosphoinositide 3 kinase regulatory subunit 2(beta); p85 beta; p85-BETA; P85B; PI3 Kinase p85 beta; |
| 产品应用 | WB=1:500-2000, IHC-P=1:100-500, IHC-F=1:100-500, IF=1:100-500 Not yet tested in other applications. |
| 交叉反应 | Human, Mouse, Rat (Dog, Cow) |
| 抗体来源 | Rabbit |
| 免疫原 | KLH conjugated synthetic peptide derived from human PI 3 Kinase p85 beta |
| 亚型 | IgG |
| 性状 | Liquid |
| 纯化方法 | affinity purified by Protein A |
| 克隆类型 | Polyclonal |
| 理论分子量 | 82 kDa |
| 浓度 | 1mg/ml |
| 储存液 | 0.01M TBS (pH7.4) with 1% BSA, 0.02% Proclin300 and 50% Glycerol. |
| 研究领域 | Immunology > Innate Immunity > TLR Signaling Signal Transduction > Signaling Pathway > Lipid Signaling > Lipid Kinases |
| 亚基 | Heterodimer of a regulatory subunit PIK3R2 and a p110 catalytic subunit (PIK3CA, PIK3CB or PIK3CD). Interacts with AXL. Interacts with FLT1 (tyrosine-phosphorylated) and FLT4 (tyrosine-phosphorylated). Interacts with NYAP1, NYAP2 and MYO16. |
| 翻译后修饰 | Phosphorylated in response to signaling from activated receptor-type protein kinases. Dephosphorylated by PTPRJ. |
| 相似性 | Belongs to the PI3K p85 subunit family.
Contains 1 Rho-GAP domain. Contains 2 SH2 domains. Contains 1 SH3 domain. |
| 功能 | Binds to activated (phosphorylated) protein-tyrosine kinases, through its SH2 domain, and acts as an adapter, mediating the association of the p110 catalytic unit to the plasma membrane. |
| 保存条件 | Shipped at 4℃. Store at -20℃ for one year. Avoid repeated freeze/thaw cycles. |
| 注意事项 | This product as supplied is intended for research use only, not for use in human, therapeutic or diagnostic applications. |
| 背景资料 | Phosphatidylinositol 3-kinase (PI3K) is a lipid kinase that phosphorylates phosphatidylinositol and similar compounds, creating second messengers important in growth signaling pathways. PI3K functions as a heterodimer of a regulatory and a catalytic subunit. The protein encoded by this gene is a regulatory component of PI3K. Two transcript variants, one protein coding and the other non-protein coding, have been found for this gene. [provided by RefSeq, Dec 2012] |
| 应用 | 推荐稀释比例 |
| {WB} | {1:500-2000} |
| {IHC-P} | {1:100-500} |
| {IHC-F} | {1:100-500} |
| {IF} | {1:100-500} |

Primary: Anti- PI 3 Kinase p85 beta (bs-4160R) at 1/300 dilution
Secondary: HRP conjugated Goat-Anti-rabbit IgG (bs-0295G-HRP) at 1/5000 dilution
Predicted band size: 82 kD
Observed band size: 85 kD



Lane 1: Mouse Muscle tissue lysates
Lane 2: Rat Muscle tissue lysates
Primary: Anti-PIK3R2 (bs-4160R) at 1/1000 dilution
Secondary: IRDye800CW Goat Anti-Rabbit IgG at 1/20000 dilution
Predicted band size: 82 kDa
Observed band size: 90 kDa
风险提示:丁香通仅作为第三方平台,为商家信息发布提供平台空间。用户咨询产品时请注意保护个人信息及财产安全,合理判断,谨慎选购商品,商家和用户对交易行为负责。对于医疗器械类产品,请先查证核实企业经营资质和医疗器械产品注册证情况。
文献和实验[IF={{ 7.8 }}] {Hongbo Ai. et al. Osteoclast-derived apoptotic bodies accelerate the pathological progression of osteoarthritis via disturbing subchondral bone remodeling. J ORTHOP TRANSL. 2025 Mar;51:108} {WB} {Mouse}
[IF={{ 3.895 }}] {Yin H et al. T-2 Toxin Induces Oxidative Stress, Apoptosis and Cytoprotective Autophagy in Chicken Hepatocytes. Toxins (Basel). 2020 Jan 29;12(2).} {WB} {Chicken}
技术资料暂无技术资料 索取技术资料







